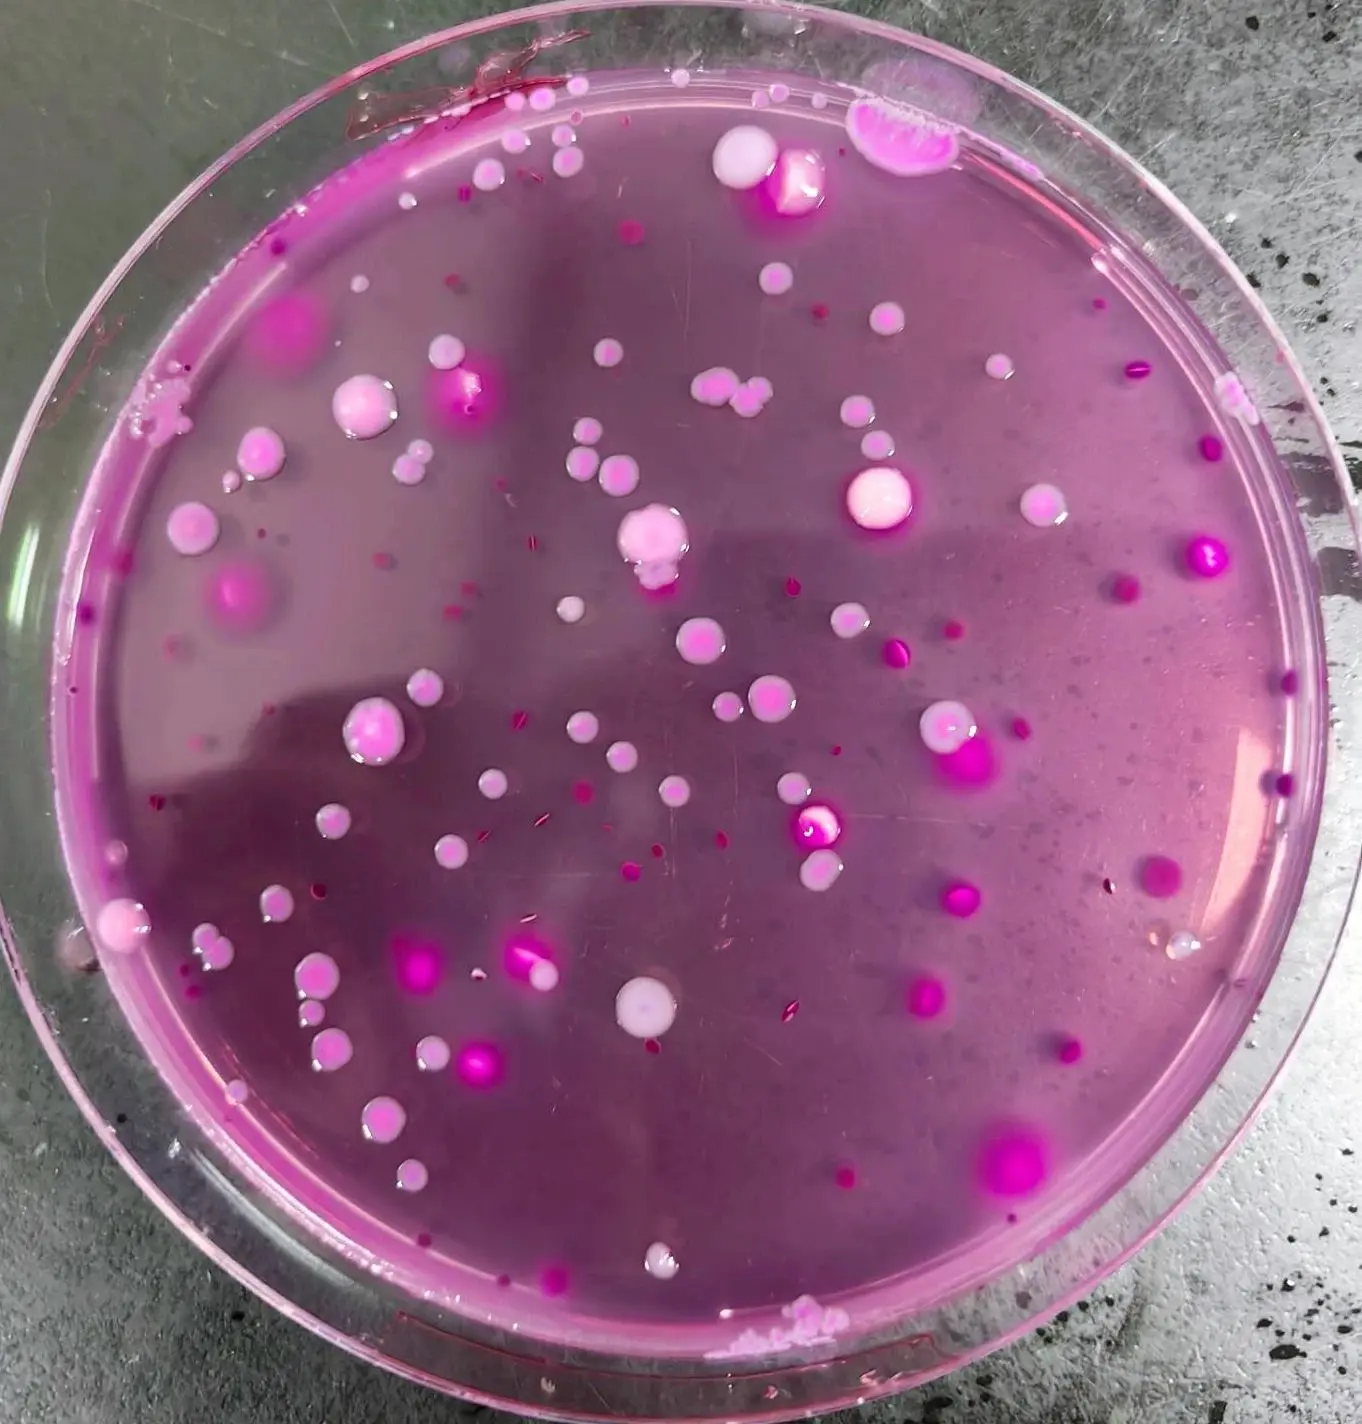
VRBA平板培养基菌落特征

标准解读│GB 4789.3-2025《食品安全国家标准 食品微生物学检验 大肠菌群计数》
发布时间:2025-05-22 浏览次数:4929
近日,国家市场监管总局发布了 GB 4789.3-2025《食品安全国家标准 食品微生物学检验 大肠菌群计数》(下称新标准)。新标准将代替 GB 4789.3-2016 并于2025年9月16日实施。
大肠菌群作为食品卫生安全重要的指标菌,其检测结果直接影响企业对产品质量的把控。此次新标准在结果处理、计数上做了详细规定,使检测结果更科学更准确。
那么新标准具体有哪些变化呢?跟着小编一起来看看吧!
1、测试片的使用
新标准正式将大肠菌群计数测试片纳入标准方法体系,同时也明确了测试片的性能要求:应以发酵乳糖产酸产气为阳性结果判断依据,且性能符合GB 4789.28 中相关培养基的质量要求。
测试片法凭借其操作简单、计数快捷的优势,使整个实验流程变得更加高效、便捷,结束繁琐的VRBA培养基配置步骤。
2、菌落的挑取
日常检测过程中大家会不会疑惑,应如何挑取确证试验中典型菌落和可疑菌落?按照GB 4789.3-2016,挑取10个不同类型的典型和可疑菌落,是指长得不一样的可疑菌落,还是典型和可疑的菌落随意选择?
为此,新标准中做了明确规定:典型和可疑菌落分开计数,各挑取5个验证。此外新标准附录D中,还详细列举了各种情况的计算方法。
3、乳及乳制品培养温度
新标准中,对乳及乳制品平板计数的培养温度调整为30℃±1℃。为何做此调整,可能基于以下两个原因:
① 标准修订过程中通过大量实验数据发现,乳及乳制品样品无论是常规的VRBA平板计数还是测试片计数,30℃的培养温度计数结果均显著高于36℃的培养数值。由此可见,采用30℃培养温度能够提高结果的准确性。
② 国外的权威标准,对乳及乳制品大肠菌群平板计数法的培养温度一般都低于36℃,如ISO 4832:2006标准为 30℃,FDA BAM Chapter4(2020)标准则为32℃。因此调整乳及乳制品平板计数的培养温度可与国际标准接轨,实现“一次检测,全球通行”。
4、其他修改
① MPN检索表中增加了MPN/g(mL)与MPN/100g(mL)的换算,简单来说,把表中的数值乘以100就可以。
② 将MPN法中产气现象修改为:小导管或产气收集装置内有气泡产生,或轻轻摇振试管可见有细密气泡不断上升者判断为产气。
③ 明确修约原则为“四舍五入”。
本文为网络转载,仅作分享交流,非商业用途,若涉侵权请联系删除。







